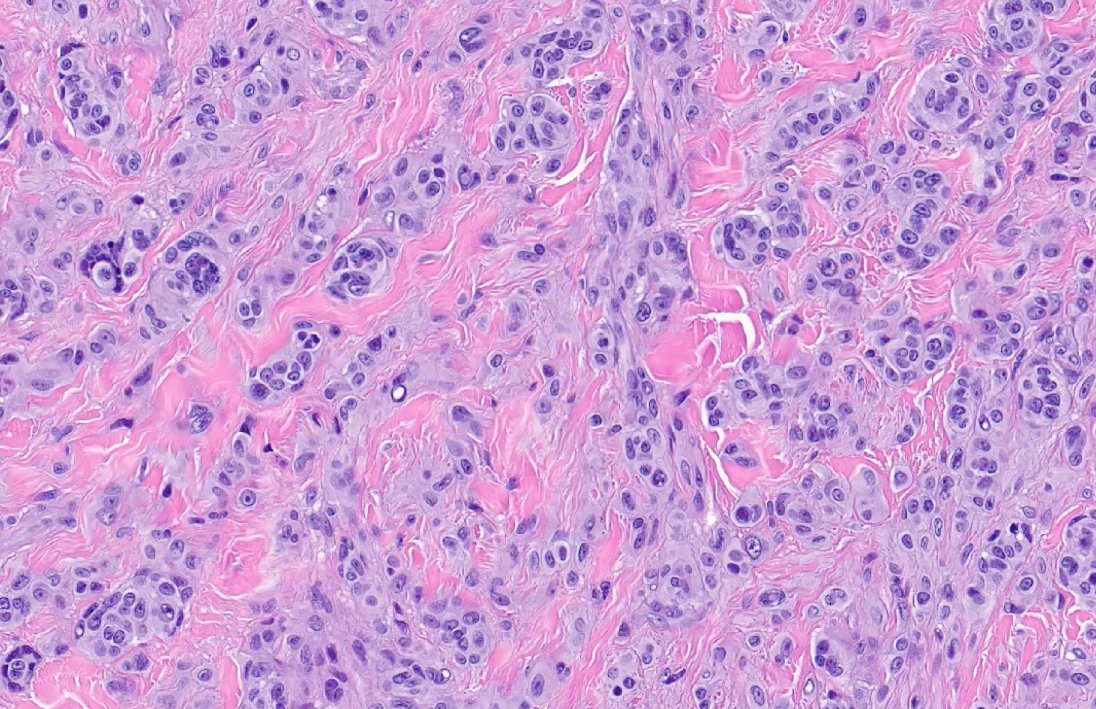
SimonRoyMD's tweet image. If you're at #ASDP2020, feel free to check out our Duel presentation about BRAF-fused Spitz tumors in a patient with ring chromosome 7 syndrome. Video accessible anytime during!

#asdp2020 search results
Check out the alopecia course #ASDP2020 @ASDPTweets! Great lectures, organized by Dr. Eleanor Knopp. Screen shot (left) from her lecture-ok to "cheat" and use the rules of thumb rather than measure each follicle! (right)-Dr. Shawn Cowper's lecture #dermpath #PathTwitter


ASDP attendees: If you purchase through our store, you can enter in a raffle to win a free book and to have a meet-and-greet with Drs. Montgomery and Gardner. Three winners will be announced. Code MEETING innovativesciencepress.com #ASDP20 #ASDP2020 @JMGardnerMD @LizMontgomeryMD

ASDP attendees: If you purchase through our store, you can enter in a raffle to win a free book and to have a meet-and-greet with Drs. Montgomery and Gardner. Three winners will be announced. Code MEETING innovativesciencepress.com #ASDP20 #ASDP2020 @JMGardnerMD @LizMontgomeryMD

p40 and P63 are reasonable markers to help determine primary adnexal CA from mets. P63 is more sensitive in primary skin CA, but p40 is more specific. #ASDP20 #asdp2020 #skincancer #metastasis @ASDPTweets

Nice pearl from Dr. Dirk Elston's ASDP lecture - tons of other pearls if you haven't tuned in yet - both images below are Histoplasma capsulatum! In the vessel, can look like Aspergillus. #ASDP2020 @ASDPTweets

Vascular tumor session with Dr Billings #ASDP2020 pyogenic granuloma can be inside a vessel #dermpath #bstpath

In early pancreatic panniculitis, you may only see some neutrophilic infiltrates without over “saponification” type necrosis. #dermpath #ASDP2020

If you're at #ASDP2020, feel free to check out our Duel presentation about BRAF-fused Spitz tumors in a patient with ring chromosome 7 syndrome. Video accessible anytime during!


I think you can still register - program available online through Feb 2021. I really enjoyed the lectures! #ASDP2020 @ASDPTweets asdp.org/annual-meeting…
CD34 can be helpful in the DDx of large neurofibroma vs desmoplastic MM. CD34 is + in a whorled fingerprint pattern in NF but is essentially neg in desmo MM (of course, both are S100+, and NF1 is the most frequent mutation in desmo MM). @ASDPTweets #ASDP20 #asdp2020 #melanoma

ERG is often positive in leukemia cutis (neg in reactive infiltrates) and certain clones of epithelial sarcoma. @KonstantinosLin @ASDPTweets #ASDP20 #asdp2020 #sarcoma #skincancer

Anyone else keep having this issue with streaming live lectures #asdp2020. It keeps ending the meeting. I relogon and it works for a little while and then ends again. I'm in chrome.

Poor man's version of WSI: stitching 30 photos taken from a low cost camera and by writing some custom Python codes. If you're interested in knowing this lesion and will be at #ASDP2020, please check my poster #563 with @VandergriffMD

Another fantastic talk by the Great Elston! Cutaneous infections. #ASDP2020 #helwiglecture The scary story of kid with diagnosis of LCH treated with alkylation agents turns out to be Scabies infestation 😱

Enjoying the expert panel short course at #ASDP2020 Fantastic opportunity to compare different approaches to interesting cases! #asdp2020 @dermpathgal @thomashelmer5 @SteveBillingsMD @FerringerTammie @GibsonLawrencee @MileHighDpath @ChristineJKoMD @MPulitzerMD


Great Fellow Presentation on the subject of atypical pleomorphic fibrolipomatous tumors by Dr. Laleh Montaser Kouhsari! @llmontaseri at #ASDP2020 Representing @BIDMCpath and #ucsfpath



In case you missed the @asdptweets Evening slide symposium cases - check them out here: Case prelim: asdp.org/annual-meeting… Link to the slides: yaledermpath.pathpresenter.net/#/public/prese… #asdp2020

Great thread🪡🧵 by .@HENRYY_MD curtesy of #ASDP2020
Check out asdp.org/annual-meeting… - program available online through Feb 2021. I really enjoyed the lectures! #ASDP2020 @ASDPTweets
I think you can still register - program available online through Feb 2021. I really enjoyed the lectures! #ASDP2020 @ASDPTweets asdp.org/annual-meeting…
Check out the alopecia course #ASDP2020 @ASDPTweets! Great lectures, organized by Dr. Eleanor Knopp. Screen shot (left) from her lecture-ok to "cheat" and use the rules of thumb rather than measure each follicle! (right)-Dr. Shawn Cowper's lecture #dermpath #PathTwitter


Nice pearl from Dr. Dirk Elston's ASDP lecture - tons of other pearls if you haven't tuned in yet - both images below are Histoplasma capsulatum! In the vessel, can look like Aspergillus. #ASDP2020 @ASDPTweets

Bravo @SimonRoyMD ! Captivating presentation and well deserved first place at the 21st Duel in Dermatopathology at #ASDP2020 #dermpath #dermatopathology #virtualmeeting
Mai Hoang had great info in her #ASDP2020 talk. This slide stood out for me as quite useful as primary v mets is a big deal!!Thank you! #dermpath #pathology

Listening (again) to Konstantinos at #ASDP2020. 2 rare soft tissue ERG+ tumors. I have not yet seen these in the skin, but will continue to hunt!! #dermpath #pathology


Just went back and listened to this again. Great pearls and nice talk Alex. #ASDP2020 #dermpath #pathology

#ASDP2020 Small round blue cell ddx and workup, soft tissue dermatopathology by Dr. Patel, consultations session.

So good! #asdp2020 🙌🏽👏🏽👏🏽👏🏽
Bravo to a really spectacular Basic Science course at #ASDP20. Enjoyed all the speakers and all the insights gained.

"Primary Cutaneous Mucinous Carcinoma in A Transplant Patient" #ASDP20 #ASDP2020 #dermpath #dermatology

Happy to share this shocking case of multisystem LCH at the 57th ASDP meeting! #ASDP2020 #dermpath @BIDMCpath
#ASDP2020 High-Risk Multisystem Langerhans Cell Histiocytosis in an Adult at Duel in Dermatopathology! @DrSimonLamothe @BIDMCpath


#ASDP2020 High-Risk Multisystem Langerhans Cell Histiocytosis in an Adult at Duel in Dermatopathology! @DrSimonLamothe @BIDMCpath


Loved this year’s basic science course! #ASDP2020
Collision and combined tumors including MCC! Also remember intraepidermal MCC! #ASDP2020 @basicsciencecourse



Come and join me today to talk about my poster "Chronic Sclerodermoid Dermatosis-Associated Aggressive Cutaneous Squamous Cell Carcinomas" and Duel abstract "Melanoma of Soft Parts with a Three-way Translocation:When a Rare Entity Becomes Even More Complicated" #ASDP2020


#ASDP2020 Duel of Dermatopathology Defense at 11:30-12:30CST today! BRAF-fused Spitz tumors in ring 7 syndrome. Excerpt and animation of the fusion arising from an inversion. Also, if you have encountered such a case, we are currently recruiting for our genomics study.
ASDP attendees: If you purchase through our store, you can enter in a raffle to win a free book and to have a meet-and-greet with Drs. Montgomery and Gardner. Three winners will be announced. Code MEETING innovativesciencepress.com #ASDP20 #ASDP2020 @JMGardnerMD @LizMontgomeryMD

Good panels to consider when suspicious for MF. Many now start with the panel on the right then add other IHC stains as needed. #ASDP20 #asdp2020 #lymphoma #asdptweets @ASDPTweets

If you're at #ASDP2020, feel free to check out our Duel presentation about BRAF-fused Spitz tumors in a patient with ring chromosome 7 syndrome. Video accessible anytime during!

Vascular tumor session with Dr Billings #ASDP2020 pyogenic granuloma can be inside a vessel #dermpath #bstpath

Check out the alopecia course #ASDP2020 @ASDPTweets! Great lectures, organized by Dr. Eleanor Knopp. Screen shot (left) from her lecture-ok to "cheat" and use the rules of thumb rather than measure each follicle! (right)-Dr. Shawn Cowper's lecture #dermpath #PathTwitter


When your publication on EMPSGC gets a mention in the first short course of the ASDP 2020 meeting—feeling special @DDBennettMD @NeuroEyepath @MilmanTatyana @PaulPhelpsMD @ASDPTweets @UChicagoPath @JMGardnerMD @ProfRScolyerMIA @MightyDermPath #ASDP20 #asdp2020 #empsgc


Enjoying the expert panel short course at #ASDP2020 Fantastic opportunity to compare different approaches to interesting cases! #asdp2020 @dermpathgal @thomashelmer5 @SteveBillingsMD @FerringerTammie @GibsonLawrencee @MileHighDpath @ChristineJKoMD @MPulitzerMD


#ASDP2020 High-Risk Multisystem Langerhans Cell Histiocytosis in an Adult at Duel in Dermatopathology! @DrSimonLamothe @BIDMCpath


Anyone else keep having this issue with streaming live lectures #asdp2020. It keeps ending the meeting. I relogon and it works for a little while and then ends again. I'm in chrome.

ERG is often positive in leukemia cutis (neg in reactive infiltrates) and certain clones of epithelial sarcoma. @KonstantinosLin @ASDPTweets #ASDP20 #asdp2020 #sarcoma #skincancer

CD34 can be helpful in the DDx of large neurofibroma vs desmoplastic MM. CD34 is + in a whorled fingerprint pattern in NF but is essentially neg in desmo MM (of course, both are S100+, and NF1 is the most frequent mutation in desmo MM). @ASDPTweets #ASDP20 #asdp2020 #melanoma


"Primary Cutaneous Mucinous Carcinoma in A Transplant Patient" #ASDP20 #ASDP2020 #dermpath #dermatology

Whew: Cryptococcus like vasculopathy👀! Who would have thought? Terrific presentation during evening slide symposium by Dr. Oluwakemi Onajin! @JuliaSLehmanMD @JMGardnerMD #ASDP2020 #ASDP20

Some highlights of #ASDP2020 Translational Dermatopathology, lecture by my great research mentor Dr. Iwei Yeh who is truly advancing the field of melanocytic neoplasia. Clarifications regarding Spitz versus Spitzoid, and results from her Spitzoid versus Spitz melanoma recent pub.




We're Going Virtual! #ASDP2020 is a virtual event in 2020. We anticipate a dynamic mixture of live interactive activities & pre-recorded sessions available for registrants to view on demand. Plans are in process; details to come!

Poor man's version of WSI: stitching 30 photos taken from a low cost camera and by writing some custom Python codes. If you're interested in knowing this lesion and will be at #ASDP2020, please check my poster #563 with @VandergriffMD

INSM1 is a good neuroendocrine marker helpful in dx of Merkel cell carcinoma. Remember, some MCC can be patchy with chromogranin and can even be CK7+. #ASDP20 #asdp2020 #asdptweets #dermpath #dermatopathology #skincancer #merkelcellcarcinoma @ASDPTweets

Something went wrong.
Something went wrong.
United States Trends
- 1. Graceland N/A
- 2. Elvis N/A
- 3. Election Day N/A
- 4. Moana N/A
- 5. The ACA N/A
- 6. Homeward Bound N/A
- 7. Double OT N/A
- 8. Wonder Man N/A
- 9. Solange N/A
- 10. Star Trek N/A
- 11. Apple Maps N/A
- 12. Maui N/A
- 13. #STREAMINGARIRANG N/A
- 14. Affordable Care Act N/A
- 15. Travis Kelce N/A
- 16. The Rock N/A
- 17. Carson Benge N/A
- 18. #NationalPuppyDay N/A
- 19. Corgi N/A
- 20. Starfleet Academy N/A



























